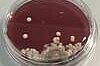
Lebensmittelmikrobiologie Labor

Der erste Kontakt ...
Girls'Day 25.04.2024
................................................................................................................................................................................................
An diesem Tag können Schülerinnen Einblicke in die technischen Tätigkeitsfelder an der HAW Hamburg erhalten. Anhand von praktischen Beispielen erleben die Schülerinnen in Laboren wie interessant und spannend diese Arbeit sein kann. Der Girls' Day richtet sich an alle Schülerinnen allgemeinbildender Schulen ab Klasse 5, schwerpunktmäßig bis Klasse 10.
Ab Mitte März stehen die Angebote in der Girls'Day Datenbank. Die Anmeldung erfolgt nur über die Datenbank unter http://www.girls-day.de/Girls_Day-Radar
Medienkompetenzzentrum
................................................................................................................................................................................................
Das Medienkompetenzzentrum (Kunst- und Mediencampus Finkenau, Raum U29a) des Departments Information der HAW Hamburg ist Projekten der Lese- und Medienkompetenzförderung gewidmet. Im Sommersemester 2017 erarbeiteten Studierende mithilfe von Design Thinking ein innovatives Raum- und Nutzungskonzept für den neuen Projektraum.
Das Medienkompetenzzentrum ist ein Ort zur Nutzung, Reflexion und Gestaltung digitaler Medien und Entwicklung von medienpädagogischen Konzepten und Ideen. In Kooperation mit Schulen, Kitas und Bibliotheken finden medienpädagogische Workshops und Gespräche mit Praxispartnern statt; unter anderem im Kontext studentischer Projekte wie Netzdurchblick. Auch empirische Interviews und Evaluationen im Rahmen der wissenschaftlichen Forschung werden hier durchgeführt.
Der Raum hält ein ActivBoard, einen Touchtable und flexible Raummöbel für verschiedene Veranstaltungsformate bereit. Neben einer Reihe an medienpädagogischen Handreichungen und Materialien stehen auch Texte, Methoden und Konzepte für die Umsetzung von Projekten und Themen der Medienpädagogik (wie Fake News, Big Data, Hate Speech, Cybermobbing, Games, Film und viele mehr) zur Verfügung.
Windkanal
................................................................................................................................................................................................
für Kita's und Grundschulen
Den Kindern wird vermittelt, warum ein Flugzeug fliegt und wie es steuern kann. Wichtig sind die Flügel, die das Flugzeug in der Luft halten, der Antrieb über die Triebwerke, damit es sich bewegen kann und natürlich Ruder und Klappen, damit man die Richtung ändern kann. Wie die Kräfte entstehen, wird mit einfachen Experimenten erklärt.
Gruppengröße: bis 20 SchülerInnen
Kontakt: Monika Riedel, Torsten Tubacki aerodynamik_labor (at) haw-hamburg (dot) de